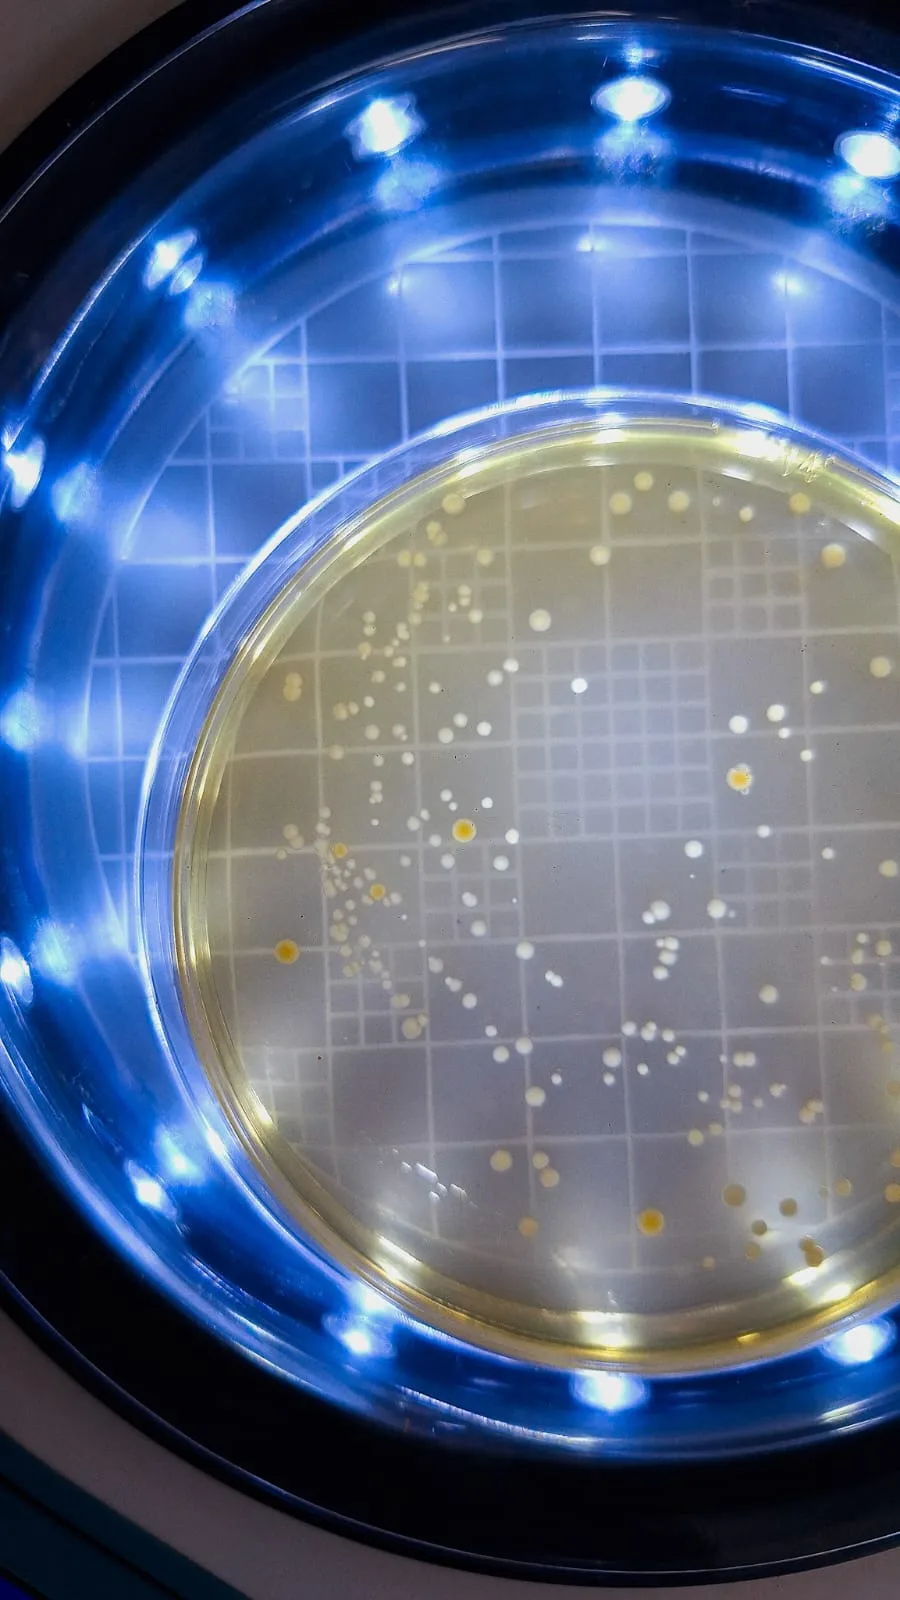

Sorofermento natural é ingrediente essencial dos queijos artesanais mineiros

Foto: Daniel Arantes – EPAMIG(São João del-Rei – 25/3/2025) O pingo, sorofermento natural, coletado da mesa de fabricação, é um ingrediente básico do queijo artesanal mineiro. Colhido na forma de soro drenado após a salga e a primeira viragem do queijo, e é, tradicionalmente, mantido em temperatura ambiente e utilizado na produção do dia seguinte.
“Neste fermento natural estão presentes diferentes tipos de bactérias láticas, responsáveis pela formação de sabor, aroma e textura típicos, que contribuem para a identidade sensorial do queijo”, define o pesquisador da Empresa de Pesquisa Agropecuária de Minas Gerais (EPAMIG) Daniel Arantes.
Quando contaminado, o pingo pode induzir a proliferação de bactérias indesejáveis, que causam defeitos como estufamento, alteração na textura e formação de sabor amargo nos queijos.
“As perdas na produção provocadas pela eventual contaminação do pingo com microrganismos indesejáveis levam alguns produtores a recorrerem a vizinhos para obter um novo fermento. Outros optam por armazená-lo na geladeira ou no congelador na própria fazenda e manter um estoque saudável”, conta Daniel Arantes, que aponta um gargalo:
“Falta conhecimento sobre os impactos desses métodos de conservação na qualidade do pingo e mesmo a definição de um tempo ideal de armazenamento nessas condições”.
Atendendo à demanda de produtores ligados à Associação dos Produtores de Queijos Artesanais de Minas do Campo das Vertentes (AQMAV), o pesquisador, que coordena o Centro de Pesquisa e Treinamento em Queijos Artesanais (CPTQA) da EPAMIG, em São João del Rei-MG, conduziu um estudo para determinar os modos de conservação e armazenamento do pingo.

“Queremos manter um padrão na qualidade dos nossos queijos e essa análise do pingo é fundamental”, opina a produtora Joelma Taroco. A queijaria da família, em São João del-Rei, participou das avaliações. “Ter pingo guardado é importante para eventualidades, mas é fundamental sabermos por quanto tempo este fermento conserva suas propriedades”.
Joelma, que além de gerenciar as atividades da queijaria, ajuda a mãe na feitura dos queijos, aponta mais vantagens do estudo. “A identificação das bactérias boas e a determinação da quantidade de pingo que devemos usar na fabricação do queijo”.
O projeto, financiado pela Fundação de Amparo à Pesquisa do Estado de Minas Gerais (Fapemig), selecionou cinco queijarias artesanais da região Campo das Vertentes, registradas no Instituto Mineiro de Agropecuária (IMA) e que atendem aos critérios sanitários vigentes.
Metodologia
“As amostras foram recolhidas em frascos esterilizados até 12 horas após a fabricação do queijo e fracionadas para serem submetidas aos tipos de armazenamento que refletem as condições que os produtores de queijos artesanais da região utilizam”, descreve Daniel Arantes.
O experimento analisou os efeitos do armazenamento refrigerado (4 a 8°C) e congelado (abaixo de -20°C) sobre as bactérias láticas, essenciais para o desenvolvimento do sabor e da textura dos queijos artesanais. Esses microrganismos desempenham também um papel fundamental na inibição de bactérias indesejáveis ao longo da maturação.
Os resultados mostraram que a refrigeração até o terceiro dia preserva as contagens de bactérias láticas num nível desejável para o uso do pingo. Já o congelamento até o décimo dia, mesmo com uma pequena redução no número de bactérias láticas, pode ser uma alternativa viável em função da redução das concentrações de alguns dos microrganismos indesejáveis avaliados.
Perspectivas futuras
Uma nova pesquisa aprovada no Edital 12/2024 “Estudo do fermento endógeno dos Queijos Artesanais em Minas Gerais: do uso empírico ao conhecimento científico e tecnológico”, também coordenada pelo pesquisador Daniel Arantes, vai expandir o estudo para outras regiões produtoras.
“Mesmo com um fluxograma de produção reconhecido, é possível perceber variações significativas nos processos de produção nas diferentes regiões reconhecidas como produtoras de Queijo Minas Artesanal, em especial da quantidade de “pingo” e sal adicionada. Isso é importante, pois cada produtor consegue imprimir uma identidade própria ao seu queijo”, aponta o pesquisador.
O trabalho, que teve início no mês de fevereiro, conta com professores e pesquisadores da Rede Mineira de Pesquisa em Queijos Artesanais de diferentes instituições localizadas próximas das regiões produtoras de queijos artesanais de modo a otimizar a logística de coleta e análise das amostras.